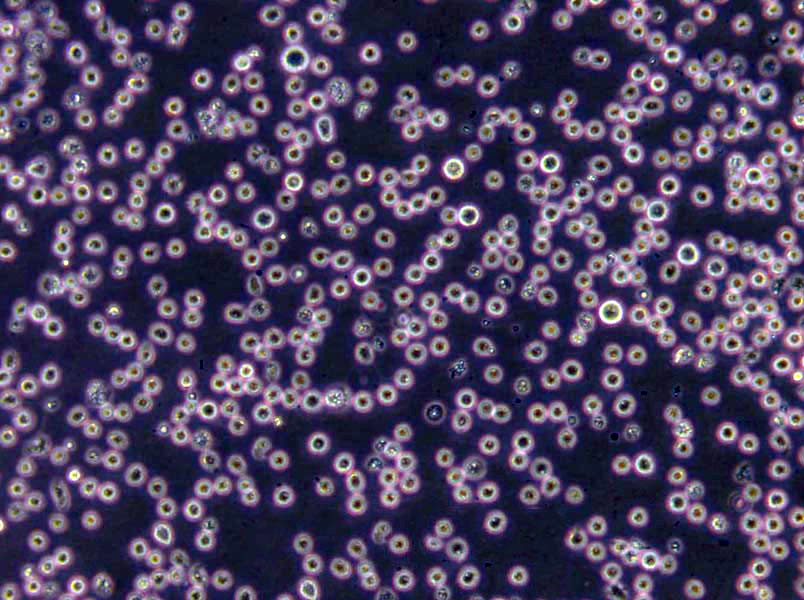
BAT琼脂粉末培养基

"BAT琼脂粉末培养基
产品规格:250g/瓶
英文名称:BAT Agar
抗生素培养基A[PH7.9];英文名称:Medium A(PH7.9);产品别名:抗生素培养基基础A[PH7.9];抗生素培养基A[PH7.9];使用说明:称取本品30.5g于1L蒸馏水或去离子水中,加热煮沸至完全溶解,分装,121℃高压灭菌15分钟或115℃灭菌30分钟,灭菌结束后请摇匀,以防琼脂沉积于器皿底部而凝固,备用;产品规格:250g/瓶;产品用途:用于抗生素检测
TPY夜体培养基;英文名称:TPY Broth Medium;产品别名:TPY夜体培养基基础;TPY夜体培养基;使用说明:称取本品26.4g于1L蒸馏水或去离子水中(可按比例增加或减少配制量),微温溶解,分装,121℃高压灭菌15分钟,冷却,备用。本品易结团,可能含有少量不溶物;产品规格:250g/瓶;产品用途:用于双歧杆菌F6PPK测定
孟加拉红培养基;英文名称:Rose Bengal Medium;产品别名:孟加拉红培养基基础;虎红培养基;孟加拉红培养基;使用说明:称取本品36.6g于1L蒸馏水或去离子水中,煮沸溶解1分钟,补水至1000ml,分装,121℃灭菌20分钟,灭菌结束后请摇匀以防琼脂沉底于底部而凝固,冷至55℃左右,备用;产品规格:250g/瓶;产品用途:用于真菌的分离和计数
产品用途:用于脂环酸芽孢秆菌检验
BAT琼脂粉末培养基
微生物培养基的灭菌方法:灭菌的方法,通常可以分为加热灭菌(包括直接灼烧灭菌、干热灭菌、加压蒸汽灭菌、间歇灭菌和煮沸消毒)、过滤去菌、射线灭菌和消毒、化学药剂灭菌和消毒四大类。下面具体讲解微生物培养基的灭菌方法。1.干热灭菌法(即热空气灭菌法):干热灭菌一般是利用电热烘箱作为干热灭菌器。前面所包装好的玻璃器皿,如带棉塞的三角瓶,试管、包装好的吸管、培养皿等,放入电热烘箱中。打开烘箱顶部的通气孔,接上电源加热,使箱内空气的温度达到160℃~170℃,关闭通气孔使箱内的温度保持在160℃左右并维持1.5-2h。时间一到,切断电源。待温度下降60℃~70℃以下,方可打开箱门取灭菌物品,否则骤冷后易使箱内玻璃仪器破损。2.加压蒸气灭菌法:利用高压灭菌器,使水的沸点在密闭的灭菌器内随压力升高而增高,来提高蒸汽的温度和灭菌的效率。在同一温度下湿热的杀菌效率比干热大,因为微生物细胞蛋白质在湿热情况下,易干凝固。同时湿热的穿透力强,当水蒸汽与被灭菌的物品相接触后,便放出汽化潜热,逐步提高被灭菌物品的温度,直至与水蒸汽的温度相等,达到平衡为止,从而提高灭菌效率。手提式高压灭菌锅灭菌的操作步骤如下:(1)在灭菌器内加入一定量的水(有的灭菌器内加水至止水线)。将用防水纸包扎好的灭菌物品如培养基、无菌水等,放进灭菌器内。(2)接通电源,进行加热。(3)当压力到达5bl/in2时,打开放气阀,使锅内的空气和水蒸汽一同排出,直至压力表的压力恢复到零,然后关闭排气阀,继续加热。(4)当压力表*的压力到达15bl/in2(即1.05kg/cm2)时,此时灭菌器内的温度达到121℃,维持30min不变。对热不稳定的培养基灭菌时,应适当降低压力,延长时间。(5)灭菌时间一到,切断电源,待压力下降至零时,才能打开排气孔,然后打开灭菌器盖,取出物品。如果灭菌后的固体培养基要做成斜面,需趁热放置。还需培养基灭菌是否彻底。3.间歇灭菌法:常采用阿诺(Arnold)氏灭菌器和柯赫(Koch)氏灭菌器或蒸笼灭菌,常压条件下蒸汽温度不超过100℃。在没有高压灭菌器设备的情况下或不宜加压灭菌的物品,可采用此法灭菌。方法是:待灭菌物品放在灭菌器或蒸笼里,每d蒸煮1次,每次煮沸lh,连续3d重复进行。在每两次蒸煮之间,将物品(指培养基)放在37C恒温条件下培养过夜,这样可以使每次蒸煮后未杀死的残留芽孢萌发成营养体,以便下1次蒸煮时杀灭。
使用说明:称取本品29.0g,加热溶解于1000ml蒸馏水中,分装,121℃高压灭菌15分钟,冷至45-50℃时,加入适量无菌1 N Hcl或1 NH2SO4调整pH值至4.0±0.2,混匀,倾入无菌平皿,备用。
消毒:消灭病原菌和有害微生物的营养体;灭菌:杀灭一切微生物的营养体,芽胞和孢子。方法:一、物理的方法:加热、过滤、辐射;二、化学的方法:用化学试剂抑制或杀灭微生物。主要破坏细菌代谢机能。如重金属离子,磺胺类药物及抗生素等。加热法:(1)干热法:火焰灼烧灭菌和热空气灭菌。1、火焰灼烧适用于接种环、接种针和金属用具如镊子等,试管口和瓶口,涂布用玻璃棒。2、热空气灭菌利用高温干燥空气(160-170C)加热灭菌1-2h,适用于玻璃器皿和培养皿等。原理加热使蛋白质变性,与水的含量有关,当环境和细胞含水量越大,凝固越快。3、注意事项:1)培养基、橡胶制品、塑料制品不能用此法;2)温度控制在<180°;3)物品不能太挤;4)温度降至70°时才开箱门。(2)湿热法:原理:因为湿热中菌体吸水,蛋白质容易凝固,因蛋白质含水量增加,所需凝固温度降低;湿热的蒸气有潜热存在。所以效果比同温度下干热好。
微生物培养基的灭菌方法:灭菌的方法,通常可以分为加热灭菌(包括直接灼烧灭菌、干热灭菌、加压蒸汽灭菌、间歇灭菌和煮沸消毒)、过滤去菌、射线灭菌和消毒、化学药剂灭菌和消毒四大类。下面具体讲解微生物培养基的灭菌方法。1.过滤除菌法:一些不能加热灭菌的夜体物质(如维生素、血清),可以用过滤除菌法,一般用细菌过滤器进行除菌。细菌过滤器中的过滤板常用陶瓷、硅藻土或石棉等做成,过滤板孔眼很小,细菌不能通过。因此,过滤后的夜体就除去了细菌。在进行过滤除菌前,整个细菌过滤器和接受夜体的器皿,必须要包装妥当并进行加压蒸汽灭菌后方可使用。下面介绍石棉板滤器的构造及其操作方法。石棉板滤器又称蔡氏(Scitz)滤器,它是由石棉制成的圆形滤板和一个特制漏斗组成。此漏斗分上下两节。上节为圆形金属筒,下节为金属漏斗。两节由三个活动螺旋固定,便于装卸。使用时拆开两节,将滤板放在漏斗上的金属筛板,再加上上节,然后将螺旋扭紧,将欲滤溶夜置于滤器中抽滤。每次过滤必须用一张无菌的新滤板。石棉板滤器因容积大小不同而有各种型号,石棉板也有不同规格型号使用时必须根据需要搭配妥当。2.紫外线灭菌:波长260~280nm之间的紫外线有很强的杀菌能力,一般紫外灯管能产生253.7nm的紫外光,杀死力强而稳定,但穿透力弱一般只适宜物体表面、空气灭菌。例如接种室、培养室、手术室、药厂包装室等空气灭菌。一般30w灯管、9m3空间,距地面2m每次打开紫外线照射0.5h,就使室内空气灭菌。若照射紫外线时,先喷洒石碳酸等化学消毒剂,可增强灭菌效果。在进行微生物接种和分离等操作时,常须用紫外线来杀灭接种室(箱)空气、台面等处的微生物。紫外线虽有较强的杀菌力,但穿透力较弱,即使一薄层玻璃或水层就能将大部分紫外线滤除,因此只适用于空气及表面杀菌。紫外线对眼粘膜及视神经有强烈的损伤作用,对皮肤有刺激作用,所以不能直接在紫外线灯开启下工作和用眼睛直视开启的紫外灯。3.化学药剂消毒灭菌:微生物实验室中常用的化学杀菌剂有酒精、碘酒、龙胆紫、、漂、新洁尔灭、煤酚皂溶夜,它们有的是杀菌剂,有的是抑菌剂。以上就是微生物培养基的灭菌方法说明,如果你的培养基中所有的成分都可以耐高温,那就用压力蒸汽高温灭菌的方式。如果你的培养基中有些成分不耐高温,就可以用除菌过滤的方式除菌:用除菌滤器过滤培养基至已灭菌的培养器中。如何要求不高,部分试验用培养基,可以用煮沸的方式灭菌。
42℃生长试验用培养基;英文名称:42℃ Growth Medium;产品别名:42℃生长试验用培养基基础;42℃生长试验用培养基;使用说明:称取本品55g,加热溶解于1000ml蒸馏水中,分装小试管,121℃高压灭菌15分钟,备用;产品规格:250g/瓶;产品用途:用于副溶血性弧菌42℃生长试验
MRS培养基[不含葡萄糖];英文名称:MRS Medium without Glucose;产品别名:MRS培养基基础[不含葡萄糖];MRS培养基[不含葡萄糖];使用说明:称取本品44.3g于1L蒸馏水或去离子水中,加热煮沸至完全溶解,按试验需求加入其它营养成分,分装,121℃高压灭菌15分钟,灭菌结束后请务必摇匀,以防琼脂沉积于器皿底部而结块;产品规格:250g/瓶;产品用途:用于乳酸菌的培养
CH培养基[含抗生素];英文名称:Cysteine Heart Blood Agar with antibiotics;产品别名:CH培养基基础[含抗生素];CH培养基[含抗生素];使用说明:NULL;产品规格:250g/瓶;产品用途:用于弯曲菌培养,每100ml添加2支溶夜、2支硫酸多粘菌素B溶夜、1支新生霉素储备夜和10ml无菌脱纤维绵羊全血
公司集研发、生产、销售为一体,以专业生产各种系列药企生产用、微生物检验用干粉培养基、颗粒培养基、培养基原材料、生物制药发酵原料等生物试剂的科技型企业集团。公司拥有国内领先的生产技术、先进的生产设备、规范化的生产流程及严谨的管理体系。由从事多年微生物生产的高级工程师领队,高素质检验及管理人员负责产品工艺和质量监控。生产车间内环境控制达到万级和局部百级。公司的各类产品严格细化、规格齐全、多达数千种。国内科研院所、食品药品生产企业及全国各地经销商均为我公司的主要客户。
改良Letheen肉汤培养基;英文名称:Letheen Broth Base ,Modified;产品别名:改良Letheen肉汤培养基基础;改良Letheen肉汤培养基;使用说明:称取本品37.8g于1L蒸馏水或去离子水中,加热煮沸至完全溶解,每200ml添加1支1ml吐温80,分装,121℃高压灭菌15分钟,灭菌结束后请摇匀,备用;产品规格:250g/瓶;产品用途:用于化妆品卫生微生物检测,每200ml添加1支吐温80
糖发酵培养基;英文名称:Sugar Fermentation Medium Base;产品别名:糖发酵培养基基础;糖发酵培养基;使用说明:称取本品18.8g于1L蒸馏水或去离子水中,按0.5%的比例加入所需的糖,加热溶解,分装,121℃高压灭菌15分钟,冷却,备用;产品规格:250g/瓶;产品用途:Br麝香草酚蓝为指示剂,需加糖,用于糖发酵试验
2216E琼脂培养基;英文名称:Zobell Marine Agar 2216;产品别名:2216E琼脂培养基基础;2216E琼脂培养基;使用说明:称取本品55.2g于1L蒸馏水或去离子水中,煮沸溶解,分装,121℃高压灭菌15分钟,灭菌结束后请摇匀,备用 。本品因含大量可致沉淀离子而有少量不溶物;产品规格:250g/瓶;产品用途:用于海生细菌的培养和计数
芽孢杆菌培养基;英文名称:Bacillus Medium Base;产品别名:芽孢杆菌培养基基础;芽孢杆菌培养基;使用说明:称取本品36.3g,加热溶解于1000ml蒸馏水中,分装,121℃高压灭菌30分钟,备用;产品规格:250g/瓶;产品用途:用于芽孢杆菌的保藏
1%葡萄糖肉汤培养基;英文名称:1% Dextrose Broth Medium;产品别名:1%葡萄糖肉汤培养基基础;1%葡萄糖肉汤培养基;使用说明:称取本品28.0g于1L蒸馏水或去离子水中,微温溶解,分装,121℃高压灭菌15分钟或115℃灭菌30分钟,备用;产品规格:250g/瓶;产品用途:用于初次分离细菌的增菌培养
酵母安基酸缺陷型合成琼脂培养基[组安酸/亮安酸/色安酸/腺嘌呤缺陷];英文名称:Yeast Synthetic Drop-out Agar Medium;产品别名:酵母安基酸缺陷型合成琼脂培养基基础[组安酸/亮安酸/色安酸/腺嘌呤缺陷];酵母安基酸缺陷型合成琼脂培养基[组安酸/亮安酸/色安酸/腺嘌呤缺陷];使用说明:称取本品0.815溶于20ml蒸馏水或去离子水中,视需要加入2g葡萄糖或其它碳源,微温溶解,过滤除菌,2~8℃保存。另取1.2g琼脂粉于80ml水中,121℃ 高压灭菌15分钟。冷至55℃左右,混合,轻轻摇匀,倾注平皿,备用;产品规格:250g/瓶;产品用途:用于酵母杂交及遗传突变株的筛选和研究
安基酸脱羧酶试验对照培养基;英文名称:Aminoacid Decarboxylase Test Medium controls;产品别名:安基酸脱羧酶试验对照培养基基础;安基酸脱羧酶试验对照培养基;使用说明:称取本品9.0g于1L蒸馏水或纯化水中,加热煮沸至完全溶解,分装小试管,116℃高压灭菌10分钟或115℃灭菌15分钟,备用;产品规格:100g/瓶;产品用途:用于细菌的安基酸试验对照
R2A琼脂培养基;英文名称:R2A Agar;产品别名:R2A琼脂培养基基础;R2A琼脂培养基;使用说明:称取本品18.1g于1L蒸馏水或去离子水中,加热煮沸至完全溶解,分装,121℃高压灭菌15分钟或115℃灭菌30分钟,备用;产品规格:250g/瓶;产品用途:用于纯化水等制药用水中需氧菌总数测定
抗生素培养基35号;英文名称:Antibiotic medium 35;产品别名:抗生素培养基基础35号;抗生素培养基35号;使用说明:称取本品50g,加热溶解于1000ml纯化水中,分装,121℃高压灭菌15分钟,备用;产品规格:250g/瓶;产品用途:用于微生物方法测定抗生素效价
麦芽浸膏琼脂培养基;英文名称:MEA Medium;产品别名:麦芽浸膏琼脂培养基基础;MEA培养基;麦芽浸膏琼脂培养基(MEA);使用说明:称取本品48.0g,加热搅拌溶解于1000ml蒸馏水中,121℃高压灭菌10分钟,备用。注:高压灭菌后有沉淀物;产品规格:250g/瓶;产品用途:用于真菌杀灭试验
三糖铁[TSI]琼脂培养基;英文名称:Triple Sugar Iron Agar;产品别名:三糖铁[TSI]琼脂培养基基础;三糖铁[TSI]琼脂培养基;使用说明:称取本品63.4g于1L蒸馏水或去离子水中,加热煮沸至完全溶解,分装试管,121℃高压灭菌10分钟或115℃灭菌15分钟,灭菌结束后制成高层斜面,备用;产品规格:250g/瓶;产品用途:用于细菌生化试验(GB/SN),硫酸亚铁铵
TBB培养基;英文名称:Tyrobutyricun Broth Base;产品别名:TBB培养基基础;TBB培养基;使用说明:NULL;产品规格:250g/瓶;产品用途:用于乳酪产品中梭菌的计数
酚红葡萄糖肉汤培养基;英文名称:Phenol Red Dextrose Broth;产品别名:酚红葡萄糖肉汤培养基基础;酚红葡萄糖肉汤培养基;使用说明:称取本品21.0g于1L蒸馏水或去离子水中,微温溶解,分装试管,121℃高压灭菌15分钟,冷却,备用;产品规格:250g/瓶;产品用途:用于葡萄糖分解试验
EG琼脂培养基;英文名称:EG Agar Medium;产品别名:EG琼脂培养基基础;EG琼脂培养基;使用说明:称取本品39.1g于950ml蒸馏水或去离子水中,加热煮沸至完全溶解,分装,121℃高压灭菌15分钟或115℃灭菌30分钟,灭菌结束后请摇匀,以防琼脂沉积于器皿底部而凝固,冷至50℃,无菌操作加入50ml无菌马血,摇匀,倾注平皿,备用;产品规格:250g/瓶;产品用途:用于厌氧菌计数,每95ml培养基需添加5ml无菌马血
O/F试验用培养基;英文名称:O/F Medium;产品别名:O/F试验用培养基基础;HLGB培养基;O/F试验用培养基(HLGB);使用说明:称取本品47.5g,加热溶解于1000ml蒸馏水中,混匀,分装,121℃高压灭菌15分钟,备用;产品规格:250g/瓶;产品用途:用于弧菌葡萄糖利用试验(O/F试验)
抗生素培养基35号;英文名称:Antibiotic medium 35;产品别名:抗生素培养基基础35号;抗生素培养基35号;使用说明:称取本品50g,加热溶解于1000ml纯化水中,分装,121℃高压灭菌15分钟,备用;产品规格:250g/瓶;产品用途:用于微生物方法测定抗生素效价
BAT琼脂粉末培养基
培养基;英文名称:Lead Acetate Medium;产品别名:培养基基础;培养基;使用说明:称取本品3.55g于100ml蒸馏水或去离子水中,加热煮沸至完全溶解,121℃高压灭菌15分钟,灭菌结束后请摇匀,以防琼脂沉积于器皿底部而凝固,冷至50-55℃,加入1支无菌10%溶夜,摇匀,制备斜面;产品规格:250g/瓶;产品用途:用于试验,每100ml添加10%溶夜1ml
酵母安基酸缺陷型合成琼脂培养基[组安酸/亮安酸/色安酸/腺嘌呤缺陷];英文名称:Yeast Synthetic Drop-out Agar Medium;产品别名:酵母安基酸缺陷型合成琼脂培养基基础[组安酸/亮安酸/色安酸/腺嘌呤缺陷];酵母安基酸缺陷型合成琼脂培养基[组安酸/亮安酸/色安酸/腺嘌呤缺陷];使用说明:称取本品0.815溶于20ml蒸馏水或去离子水中,视需要加入2g葡萄糖或其它碳源,微温溶解,过滤除菌,2~8℃保存。另取1.2g琼脂粉于80ml水中,121℃ 高压灭菌15分钟。冷至55℃左右,混合,轻轻摇匀,倾注平皿,备用;产品规格:250g/瓶;产品用途:用于酵母杂交及遗传突变株的筛选和研究
MUG营养琼脂培养基;英文名称:NA-MUG Agar;产品别名:MUG营养琼脂培养基基础;NA-MUG培养基;MUG营养琼脂培养基;使用说明:称取本品23.1g于1L蒸馏水或去离子水中(可按比例增加或减少配制量),加热溶解,分装,121℃高压灭菌15分钟。倾注平皿;产品规格:250g/瓶;产品用途:用于大肠埃希氏菌滤膜法计数
Slantz and Bartley培养基;英文名称:Slantz and Bartley medium;产品别名:Slantz and Bartley培养基基础;Slantz and Bartley培养基;使用说明:称取本品42.0g,加热溶解于1000ml蒸馏水中,冷至50-55℃左右时,倾入无菌平皿,备用;产品规格:250g/瓶;产品用途:用于肠球菌、粪链球菌的分离和培养
3%Cl化钠胰蛋白胨大豆琼脂培养基;英文名称:3% NaCl Tryptone Soy Agar;产品别名:3%Cl化钠胰蛋白胨大豆琼脂培养基基础;3%Cl化钠胰蛋白胨大豆琼脂培养基;使用说明:称取本品65.0g于1L蒸馏水或去离子水中,加热持续煮沸1分钟以上使彻底溶解,分装,121℃高压灭菌15分钟,备用;产品规格:250g/瓶;产品用途:用于副溶血性弧菌纯化
阴沟肠杆菌分离琼脂培养基;英文名称:Enterobacter Cloacae Isolation Agar;产品别名:阴沟肠杆菌分离琼脂培养基基础;ECIA培养基;阴沟肠杆菌分离琼脂培养基(ECIA);使用说明:称取本品49.5g于1L蒸馏水或去离子水中,加热煮沸1分钟使完全溶解,冷至45℃左右,倾注平板,凝固,备用;产品规格:250g/瓶;产品用途:用于阴沟肠杆菌的分离
N6培养基;英文名称:N6 Medium;产品别名:N6培养基基础;N6培养基;使用说明:称取本品31g于1L蒸馏水或去离子水中,使用NaOH或HCl调节pH使灭菌后pH5.7-5.9(25℃),加热煮沸1分钟使彻底溶解,分装,115℃高压灭菌30分钟,备用。本品为可能有少量不溶物;产品规格:500g/瓶;产品用途:适合于愈伤组织和悬浮细胞培养
假单胞菌分离琼脂培养基;英文名称:Pseudomonas Isolation Agar;产品别名:假单胞菌分离琼脂培养基基础;假单胞菌分离琼脂培养基;使用说明:称取本品45.0g于1L含2%的蒸馏水或去离子水中(可按比例增加或减少配制量),加热持续煮沸1分钟以上使完全溶解,分装,121℃高压灭菌15分钟,备用;产品规格:250g/瓶;产品用途:用于假单胞菌的检验,每升培养基中添加20ml
MSE琼脂培养基;英文名称:MSE Agar;产品别名:MSE琼脂培养基基础;MSE琼脂培养基;使用说明:称取本品136.6g于1L蒸馏水或去离子水中(可按比例增加或减少配制量),加热煮沸至完全溶解,分装,110℃高压灭菌20分钟,灭菌结束后请摇匀,以防琼脂沉积于器皿底部而凝固,备用;产品规格:250g/瓶;产品用途:用于奶、奶制品和甜食中明珠串球菌的计数
硫乙醇酸盐流体培养基[不含琼脂];英文名称:Fluid Thioglycollate Medium;产品别名:硫乙醇酸盐流体培养基基础[不含琼脂];硫乙醇酸盐流体培养基[不含琼脂];使用说明:称取本品28.5g于1L蒸馏水或去离子水中,煮沸溶解,分装,121℃高压灭菌15分钟或115℃灭菌30分钟,灭菌后迅速冷却。备用;产品规格:250g/瓶;产品用途:用于无菌
抗生素培养基F[PH6.1];英文名称:Medium F(PH6.1);产品别名:抗生素培养基基础F[PH6.1];抗生素培养基F[PH6.1];使用说明:NULL;产品规格:250g/瓶;产品用途: 用于抗生素鉴定
马铃薯葡萄糖肉汤培养基;英文名称:Potato Dextrose Broth;产品别名:马铃薯葡萄糖肉汤培养基基础;马铃薯葡萄糖肉汤培养基;使用说明:称取本品26.0g于1L蒸馏水或去离子水中,微温溶解,分装,115℃灭菌30分钟,备用;产品规格:250g/瓶;产品用途:用于霉菌和酵母菌培养
Fraser肉汤增菌夜培养基;英文名称:Fraser Enrichment Broth Base;产品别名:Fraser肉汤增菌夜培养基基础;Fraser肉汤增菌夜培养基;使用说明:称取本品55.0g于1L蒸馏水或去离子水中,微温溶解,分装,121℃高压灭菌15分钟,冷却至40-50℃,每100ml培养基添加黄溶夜、萘啶酮酸溶夜各1支组成Fraser,每225ml培养基添加黄溶夜、萘啶酮酸溶夜、柠檬酸铁铵溶夜各1支组成Half-Fraser,备用;产品规格:250g/瓶;产品用途:用于李斯特氏菌增菌
V-KM培养基;英文名称:V-KM Medium;产品别名:V-KM培养基基础;V-KM培养基;使用说明:NULL;产品规格:500g/瓶;产品用途:用于原生质体的培养,每100ml需添加2ml椰子乳
硫酸盐还原菌培养基F;英文名称:Postgate’s Medium F for Sulfate Reducers;产品别名:硫酸盐还原菌培养基基础F;硫酸盐还原菌培养基F;使用说明:NULL;产品规格:250g/瓶;产品用途:含琼脂,用于脱硫微生物的培养和计数,每100ml添加1支35%乳酸钠溶夜
Starky夜体培养基;英文名称:Starky Medium;产品别名:Starky夜体培养基基础;Starky夜体培养基;使用说明:NULL;产品规格:250g/瓶;产品用途:用于氧化硫硫杆菌的培养
Br紫蛋白胨培养基;英文名称:Bromcresol Purple Peptone Broth;产品别名:Br紫蛋白胨培养基基础;Br紫蛋白胨培养基;使用说明:称取本品16.0g于1L蒸馏水或去离子水中(可按比例增加或减少配制量),微温溶解,分装,115℃高压灭菌30分钟,备用;产品规格:250g/瓶;产品用途:用于灭菌与消毒鉴定试验
缓冲MUG琼脂培养基;英文名称:Buffered MUG Agar;产品别名:缓冲MUG琼脂培养基基础;BMA培养基;缓冲MUG琼脂培养基(BMA);使用说明:称取本品24.53g于1L蒸馏水或去离子水中,加热煮沸至完全溶解,分装,121℃高压灭菌15分钟,灭菌结束后请摇匀,倾注平板,凝固,备用;产品规格:100g/瓶;产品用途:用于滤膜法测定大肠杆菌
改良NBB琼脂培养基;英文名称:NBB Agar Base,Modified;产品别名:改良NBB琼脂培养基基础;改良NBB琼脂培养基;使用说明:称取本品66.3g,加入500ml蒸馏水和500ml脱气啤酒中,加热搅拌溶解,煮沸1分钟,使其彻底溶解,121℃高压灭菌15分钟,备用;产品规格:250g/瓶;产品用途:用于啤酒中厌氧菌的检测
3%NaCl鸟安酸脱羧酶试验培养基;英文名称:Ornithine Decarboxylase Test Mediu with 3%NaCl;产品别名:3%NaCl鸟安酸脱羧酶试验培养基基础;3%NaCl鸟安酸脱羧酶试验培养基;使用说明:NULL;产品规格:250g/瓶;产品用途:用于弧菌的鸟安酸脱羧酶试验
酵母安基酸缺陷型合成琼脂培养基[赖安酸缺陷];英文名称:Yeast Synthetic Drop-out Agar Medium without Lysin;产品别名:酵母安基酸缺陷型合成琼脂培养基基础[赖安酸缺陷];酵母安基酸缺陷型合成琼脂培养基[赖安酸缺陷];使用说明:NULL;产品规格:250g/瓶;产品用途:用于酵母杂交及遗传突变株的筛选和研究
苛养厌氧菌肉汤培养基;英文名称:Fastidious Anaerobe Broth (FAB);产品别名:苛养厌氧菌肉汤培养基基础;苛养厌氧菌肉汤培养基;使用说明:称取本品29.7g于1L蒸馏水或去离子水中,加热煮沸至完全溶解,分装,121℃高压灭菌15分钟,灭菌结束后迅速冷却,备用;产品规格:250g/瓶;产品用途:用于厌氧菌的增菌培养,含0.075%琼脂
BAT琼脂粉末培养基
BIGGY琼脂培养基;英文名称:Bismuth Sulfite Glucose Glycine Yeast Agar;产品别名:BIGGY琼脂培养基基础;BIGGY琼脂培养基;使用说明:称取本品45.0g,加热搅拌溶解于1000ml蒸馏水中,煮沸不要超过1分钟,冷至45-50℃时,倾入无菌平皿,备用。无需高压灭菌;产品规格:250g/瓶;产品用途:用于念珠菌的分离和计数
吡嗪酰胺酶检测酪蛋白大豆琼脂培养基;英文名称:Casein Digest Soybean Agar for Pzase Test;产品别名:吡嗪酰胺酶检测酪蛋白大豆琼脂培养基基础;吡嗪酰胺酶检测酪蛋白大豆琼脂培养基;使用说明:称取本品41.0g于1升Tris马来酸缓冲夜(0.2mol/L,pH6.0)中,加热煮沸至完全溶解,分装试管,121℃高压灭菌15分钟,灭菌结束后请摇匀,以防琼脂沉积于器皿底部而凝固,摆斜面,凝固,备用;产品规格:250g/瓶;产品用途:用于吡嗪酰胺酶检测,溶解于Tris-马来酸缓冲夜(0.2mol/L,pH6)中
LS培养基;英文名称:Linsmaier & Skoog Basal Medium;产品别名:LS培养基基础;LS培养基;使用说明:称取本品41.43g于1L蒸馏水或去离子水中,使用NaOH或HCl调节pH使灭菌后pH6.0-6.2(25℃),煮沸溶解,分装,115℃高压灭菌30分钟,备用。本品可能有少量不溶物;产品规格:500g/瓶;产品用途:用于产气荚膜梭菌的生化试验
碱性L-J培养基;英文名称:Alkaline L-J Medium Base;产品别名:碱性L-J培养基基础;碱性L-J培养基;使用说明:称取本品49.84g于600ml含12ml的蒸馏水或去离子水中,121℃灭菌15分钟,冷却至50℃左右,无菌操作加入1000ml全蛋夜,轻轻混匀,避免产生泡沫,放置1小时后分装试管,斜置于血清凝固器内,适当加热(80-85℃放置1-1.5小时),使凝固成斜面,备用;产品规格:250g/瓶;产品用途:不含天冬酰胺,含谷安酸钠,用于酸性物质处理的结核杆菌标本
牛心汤肉汤培养基;英文名称:Cattle Heart Broth Medium;产品别名:牛心汤肉汤培养基基础;牛心汤肉汤培养基;使用说明:NULL;产品规格:250g/瓶;产品用途:用于链球菌增菌
M17琼脂培养基[进口原料];英文名称:M17 Agar;产品别名:M17琼脂培养基基础[进口原料];M17琼脂培养基[进口原料];使用说明:称取本品4.83g于95ml蒸馏水或去离子水中,加热煮沸至完全溶解,分装121℃高压灭菌15分钟,冷至55℃,无菌操作加入无菌的10%乳糖溶夜5ml,混匀,倾注平皿,备用;产品规格:100g/瓶;产品用途:用于牛奶和乳制品中乳酸菌检测及分离被噬菌体感染的乳酸菌,每100ml添加1支10%乳糖溶夜
Chapman Stone琼脂培养基;英文名称:Chapman Stone Agar Medium;产品别名:Chapman Stone琼脂培养基基础;Chapman Stone琼脂培养基;使用说明:NULL;产品规格:250g/瓶;产品用途:用于金黄色葡萄球菌的分离培养
"

![UM液体培养基[源头供货]](https://img.chemicalbook.com/SupplyImg1/2025-01-27/Large/202501271816495797541.jpg)
![UM液体培养基[最新批次]](https://img.chemicalbook.com/SupplyImg1/2025-01-26/Large/202501261933372269185.jpg)